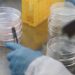

Shkencëtarët e Bio-inxhinierisë në Akademinë Shtetërore të Shkencave, në Kore të Veriut pretendojnë se kanë zbuluar një injeksion antiviral që garanton efikasitet të lartë në trajtimin e sëmundjeve të ndryshme.
Edhe pse studiuesit nuk i referohen drejtpërdrejt infeksionit Covid-19, ata shkruajnë se ilaçi i ri është efikas për sëmundjet që po përhapen me shpejtësi. Lajmi u bë i ditur nga në video e publikuar në televizionin publik KCNA, ku shikohen shkencëtarët teksa punojnë në një laborator.
“Kemi zhvilluar një injeksion antiviral që garanton efikasitet të lartë dhe mund të aplikohet në disa trajtime. Mendoj se ilaçi i ri është efikas në trajtimin e sëmundjeve të ndryshme virale që po përhapen me shpejtësi”, tha Kim Won Tae, nga Akademia e Shkencave.
Koreja e Veriut nuk ka konfirmuar ende asnjë person të infektuar me koronavirus, por ka njoftuar se ata që do të shfaqin simptoma do të vendosen në karantinë për 1 muaj. Edhe pse është një vend shumë i mbyllur për pjesën tjetër të botës, shteti komunist ka shtuar dhe kontrollet në pikat kufitare, aeroportet dhe portet detare.

Diskutime rreth kësaj post